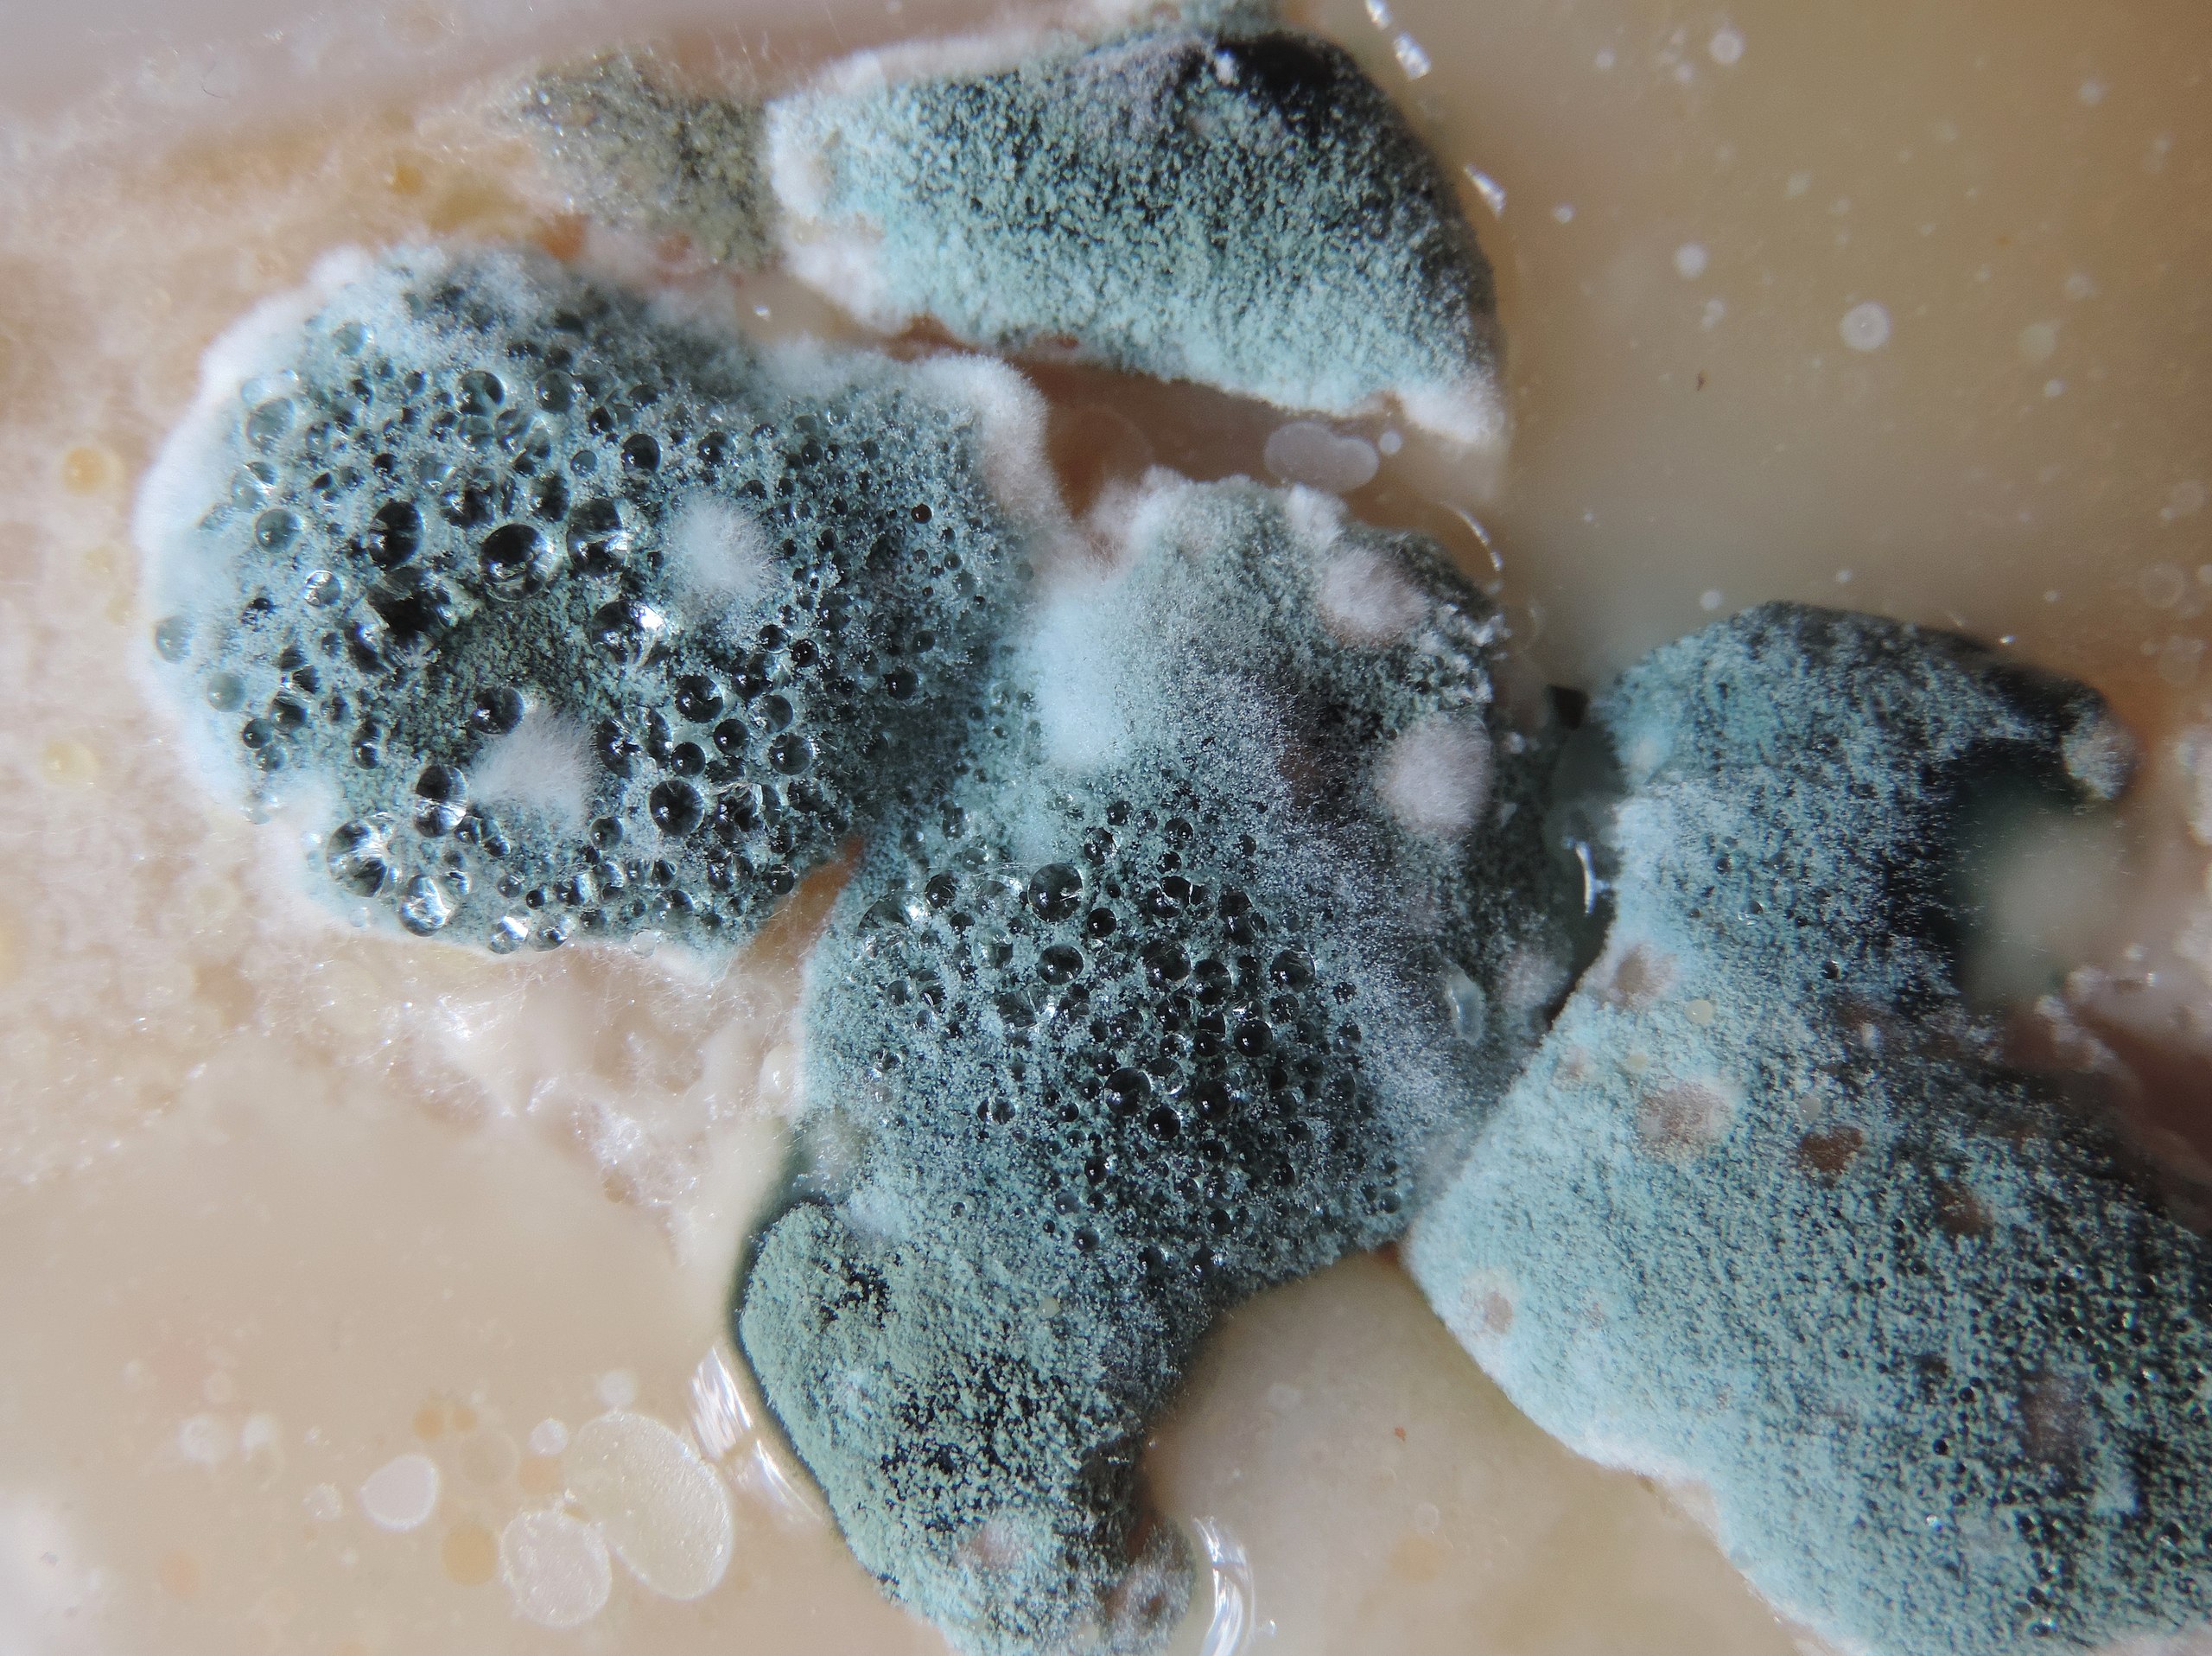

Žena začala vyzerať zle na selfie a tak zistila, že jej dom ju zabíja
Sara Smithová si myslí, že uzavrela veľmi nepríjemný obchod so svojim vlastným domom za 400 000 dolárov. Pre jej 28-ročného manžela Colina to bolo šokujúce zistenie. Svoje úspory totiž investoval do plesňou zamorenej nory.
V dôsledku toho sa Sare zhoršil zdravotný stav a tak ďalšie peniaze topia v lekárskych účtoch. Vďaka ľuďom na sociálnych sieťach, ale aj psovi, ktorý je špeciálne vycvičený na huby a plesne, zistili, čo je za tým. Jej pekelný dom ju nakoniec nedoviedol až do nemocnice.

„Jeden používateľ na Tiktoku mi povedal, aby som odtiaľ odišla,“ povedala Smithová po tom, čo sa na sociálnej sieti podelila o zistenie, že ich dom je rozsiahlo napadnutý plesňou. „Krátko po tom, čo sme sa minulý rok do domu nasťahovali, som dostala vyrážku na očných viečkach.„

Pri fotení selfie si všimla veľmi silno začervenané očné okolie. Myslela si, že zmena farby pokožky je len v dôsledku zápalu, a tak sa opýtala ľudí na sociálnych sieťach, čo si o tom myslia. Ľudia neváhali a hneď jej dali vedieť, že to môže mať niečo spoločné s jej novým domovom.

















